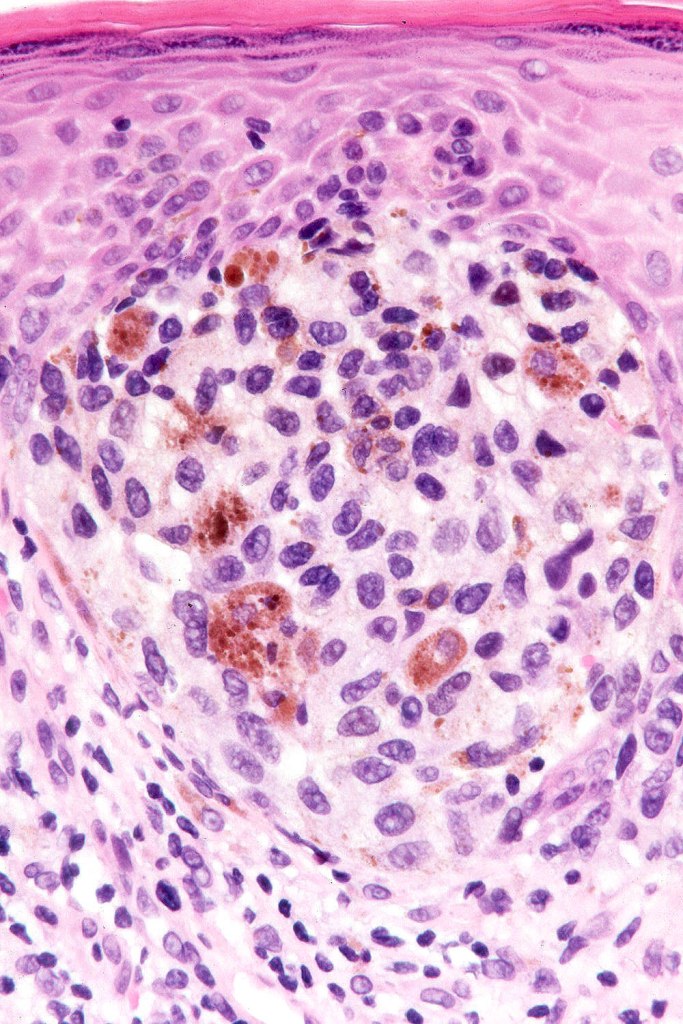
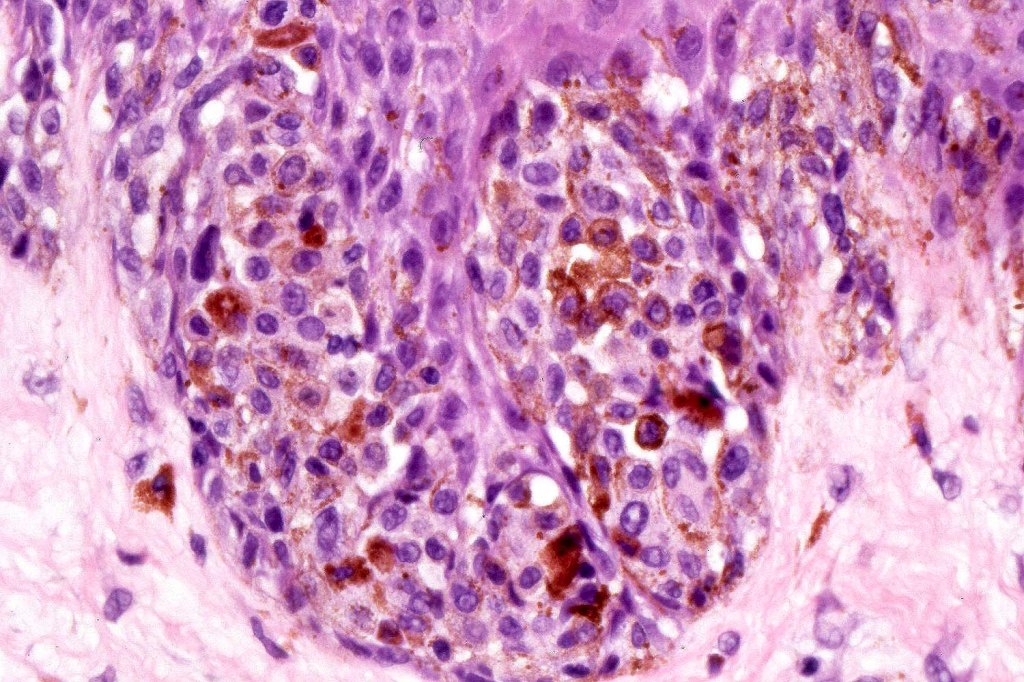
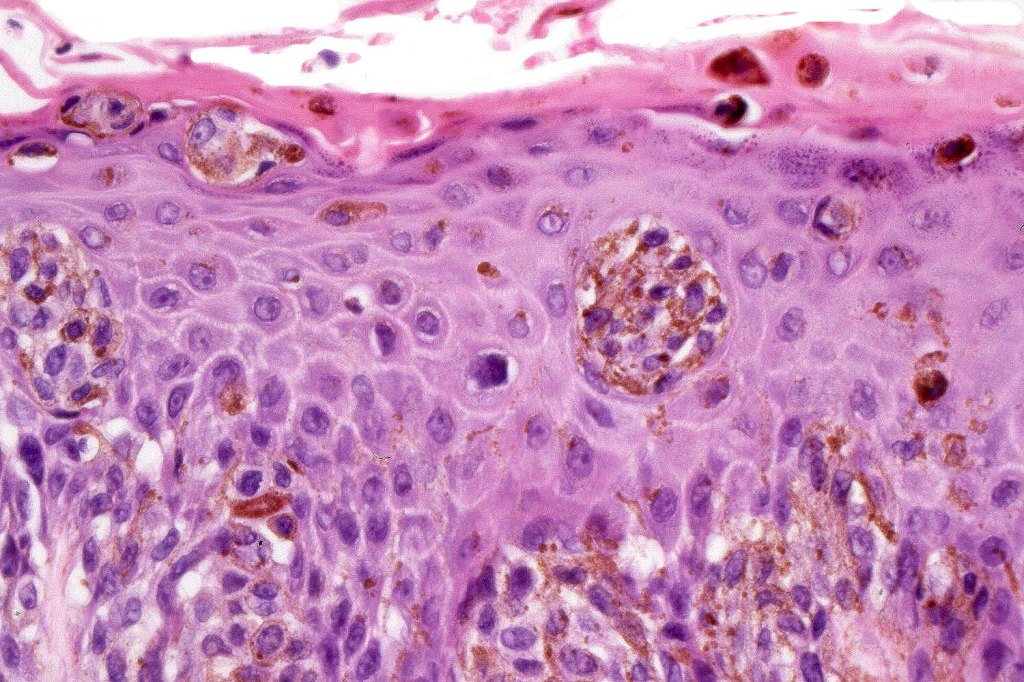
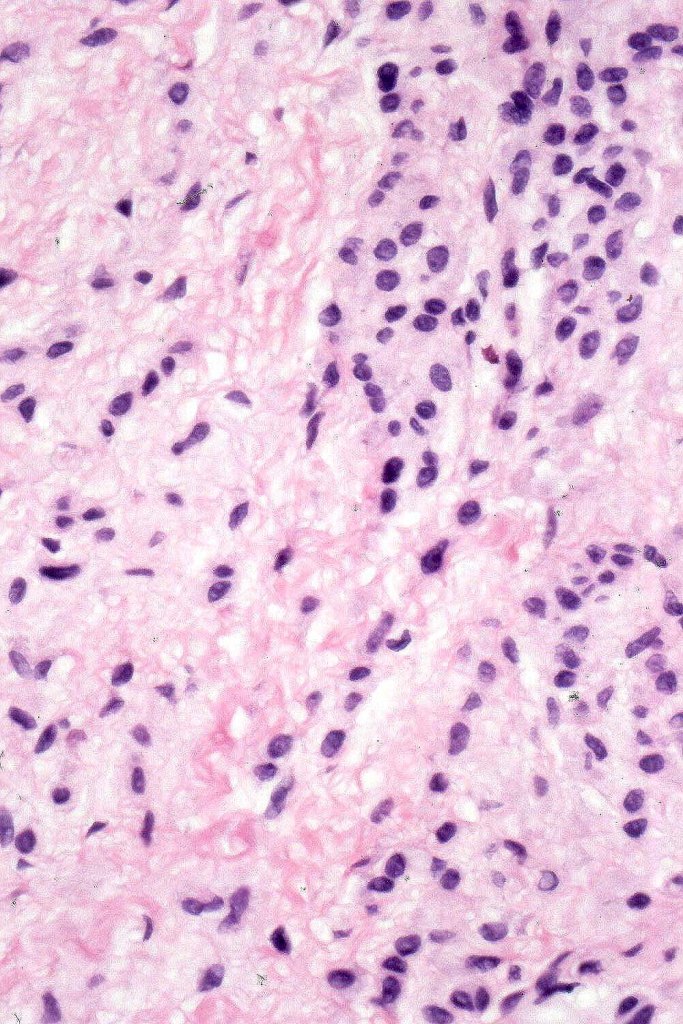
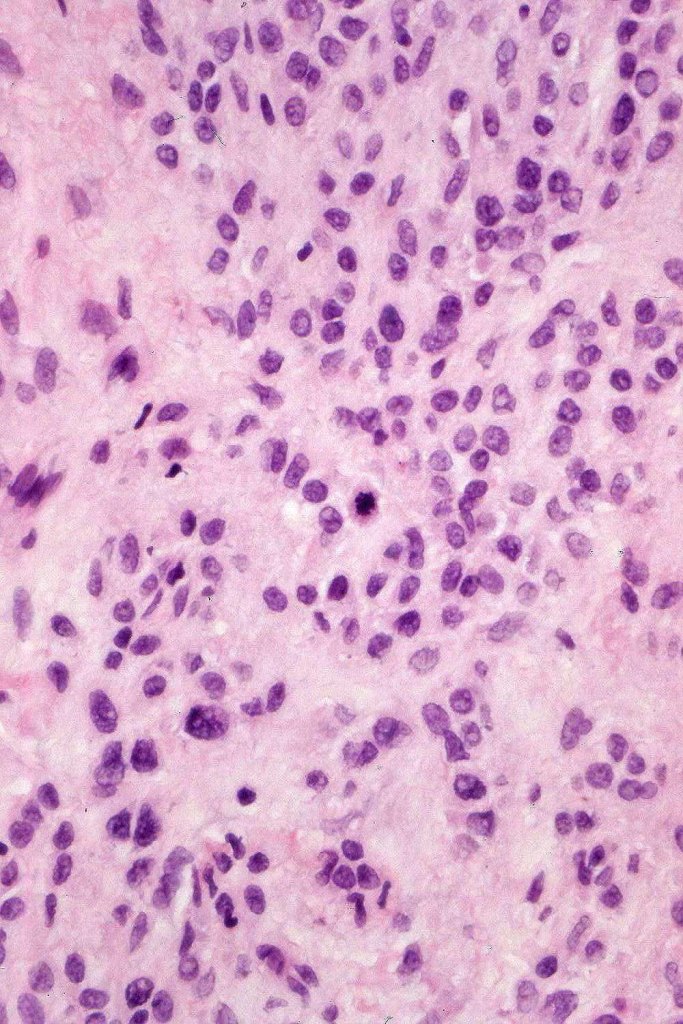
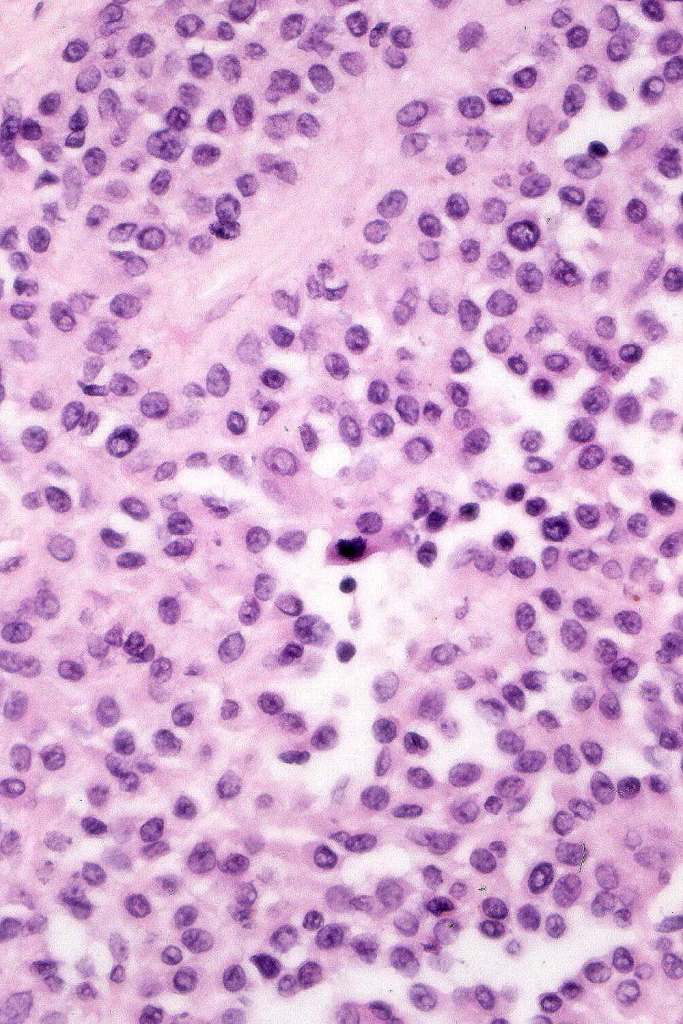
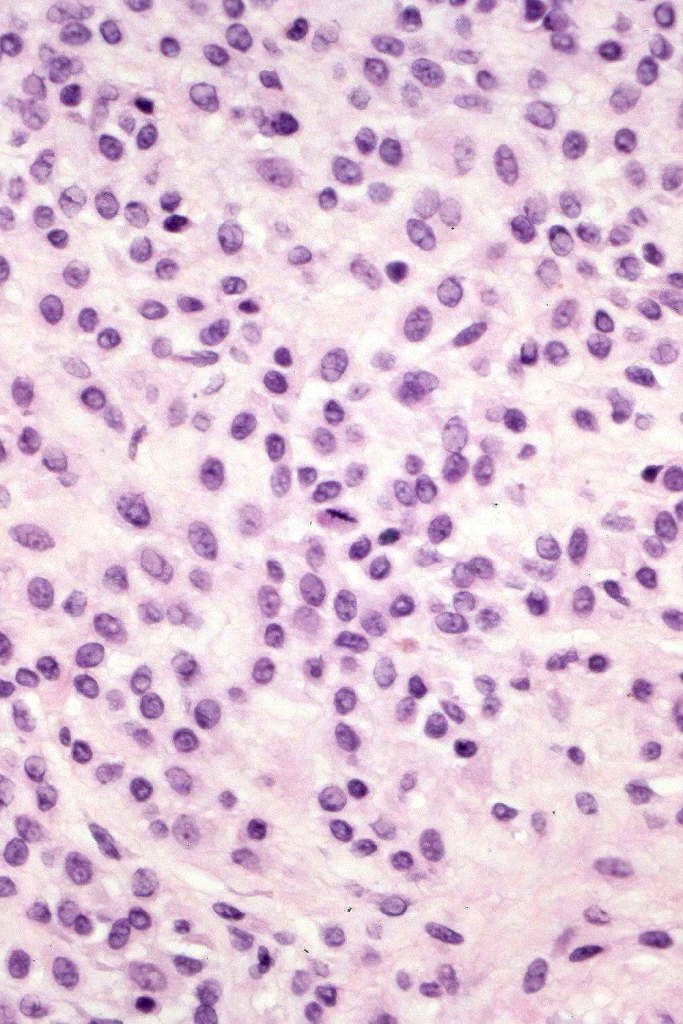
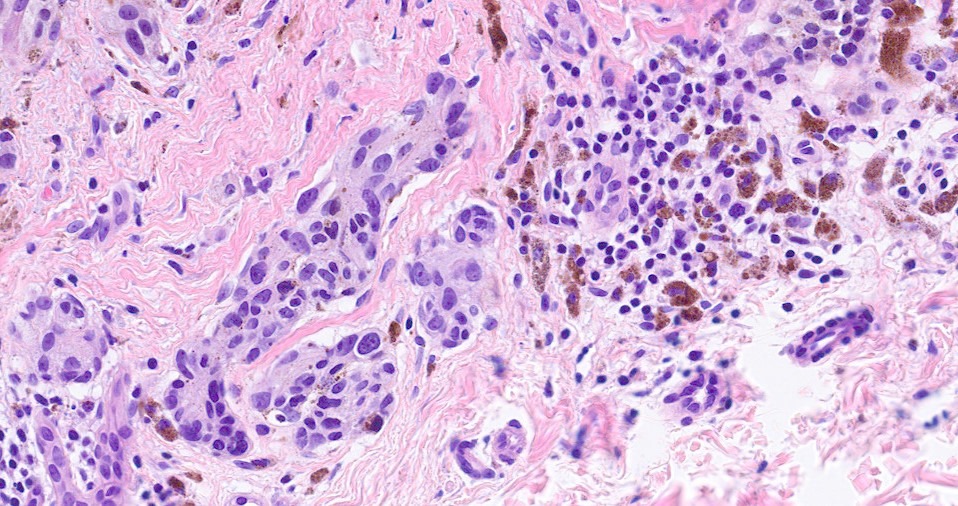
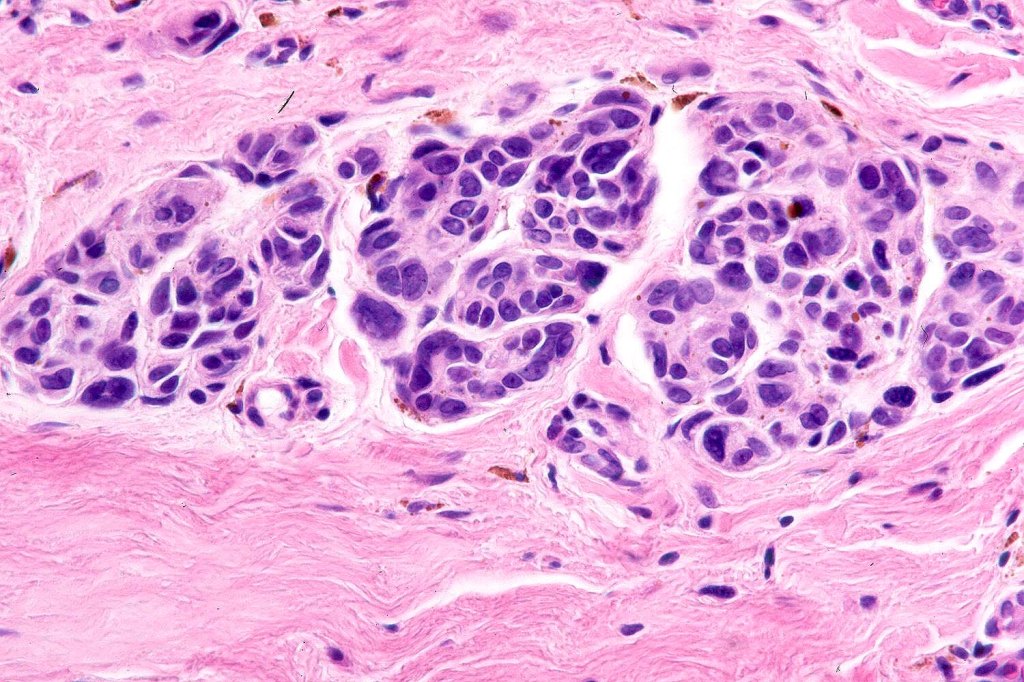

Nevi presenting in the genitalia, inguinal region, umbilicus, axilla and breast may show considerable atypia. They should be readily recognised, often at scanning magnification but may be misdiagnosed as melanoma if the age of the patient and site of the lesion are not taken into account. So-called atypical acral nevus, ear & scalp nevi are covered in separate blogs.
Clinical History
•Atypical genital nevus- vulva & adjacent skin of young women (labium majus>mons pubis>labium minus>clitoris
•In contrast, males are rarely affected
•Up to 1.0 cm irregular macules & papules
•Often discovered on routine smear
•Clinicopathological correlation critical to avoid misdiagnosis as melanoma
•Umbilical nevi can be confusing as scar tissue is to be expected
•Breast lesions are more often banal melanocytic nevi but occasionally, they show special site features


Histological features
•Junctional/compound
•Large dyscohesive nests with retraction artifact, not restricted to the tips of the epidermal ridges
•Heavy pigmentation (sometimes gray/green)
•Bridging common, often over multiple rete ridges
•Variable atypia (can be marked)
•Central pagetoid spread
•Superficial dermal atypia
•Junctional mitoses sometimes present, dermal mitoses+/-, can be multiple but never atypical
•Dermal fibrosis (sometimes lamellar)
. HMB45 shows gradation with depth, Ki67 is low

Differential diagnosis
Most important is melanoma. Distinction is best afforded by the site of the nevus and the patient’s age. Vulval melanoma is generally a tumor of the elderly. Atypical genital nevus occurs in girls and young women.
There can be overlap with dysplastic nevi although the typical architecture of the latter is absent. Large, heavily pigmented, dyscohesive nests with a retraction artifact point towards atypical genital nevus. Knowing the site of the nevus is all important.

Leave a comment